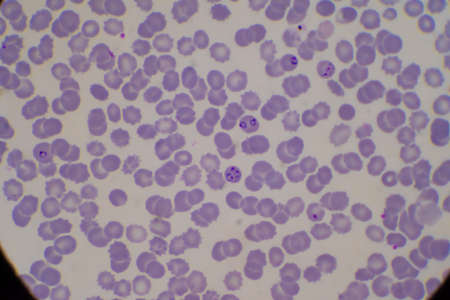
Blood parasite infected red blood cells Ring form Malaria.の写真素材

写真素材 - Blood parasite infected red blood cells Ring form Malaria.
キーワード
- anopheles
- biology
- blood
- carrier
- cell
- closeup
- detail
- diagnosis
- disease
- epidemic
- erythrocyte
- falciparum
- fever
- film
- form
- gametocyte
- health
- hematology
- illness
- infection
- infectious
- laboratory
- malaria
- medical
- medicine
- merozoite
- micro
- microorganism
- microscope
- microscopic
- microscopy
- morphology
- mosquito
- parasite
- parasitology
- pathogen
- plasmodium
- protozoan
- red
- ring
- sample
- schizont
- schuffner dots
- sick
- smear
- test
- trophozoite
- tropical
- vivax
類似作品
Healthy human r...
Blood vessel wi...
Ink liquid. Pai...
microscope slid...
flower macro ph...
Drops of blood ...
Red blood cells...
Decorations for...
old cracked woo...
Red blood cells...
Microscopic vis...
Watercolor text...
Blood vessel wi...
Red blood cells...
An artistic dis...
Fantasy chaotic...
medical microsc...
A piece of beef...
Abstract Blood ...
Hight concentra...
This stunning c...
Staphylococcus ...
Drops of blood ...
Immunity. Red b...
red coronavirus...
Itch mites unde...
Flow of particl...
Close up image ...
Red Blood Cells...
Staphylococcus ...
Babesia parasit...
Polycythemia ve...
blood in white ...
Chemical labora...
Mold on a spoil...
fingerprints ba...
The malaria-inf...
This high defin...
The malaria-inf...
Stunning and de...
3D looped anima...
Abstract painte...
Coronavirus 201...
3D illustration...
virus ebola and...
Burgundy foam. ...
Red blood cells...
Red blood cells...
Red blood cells...